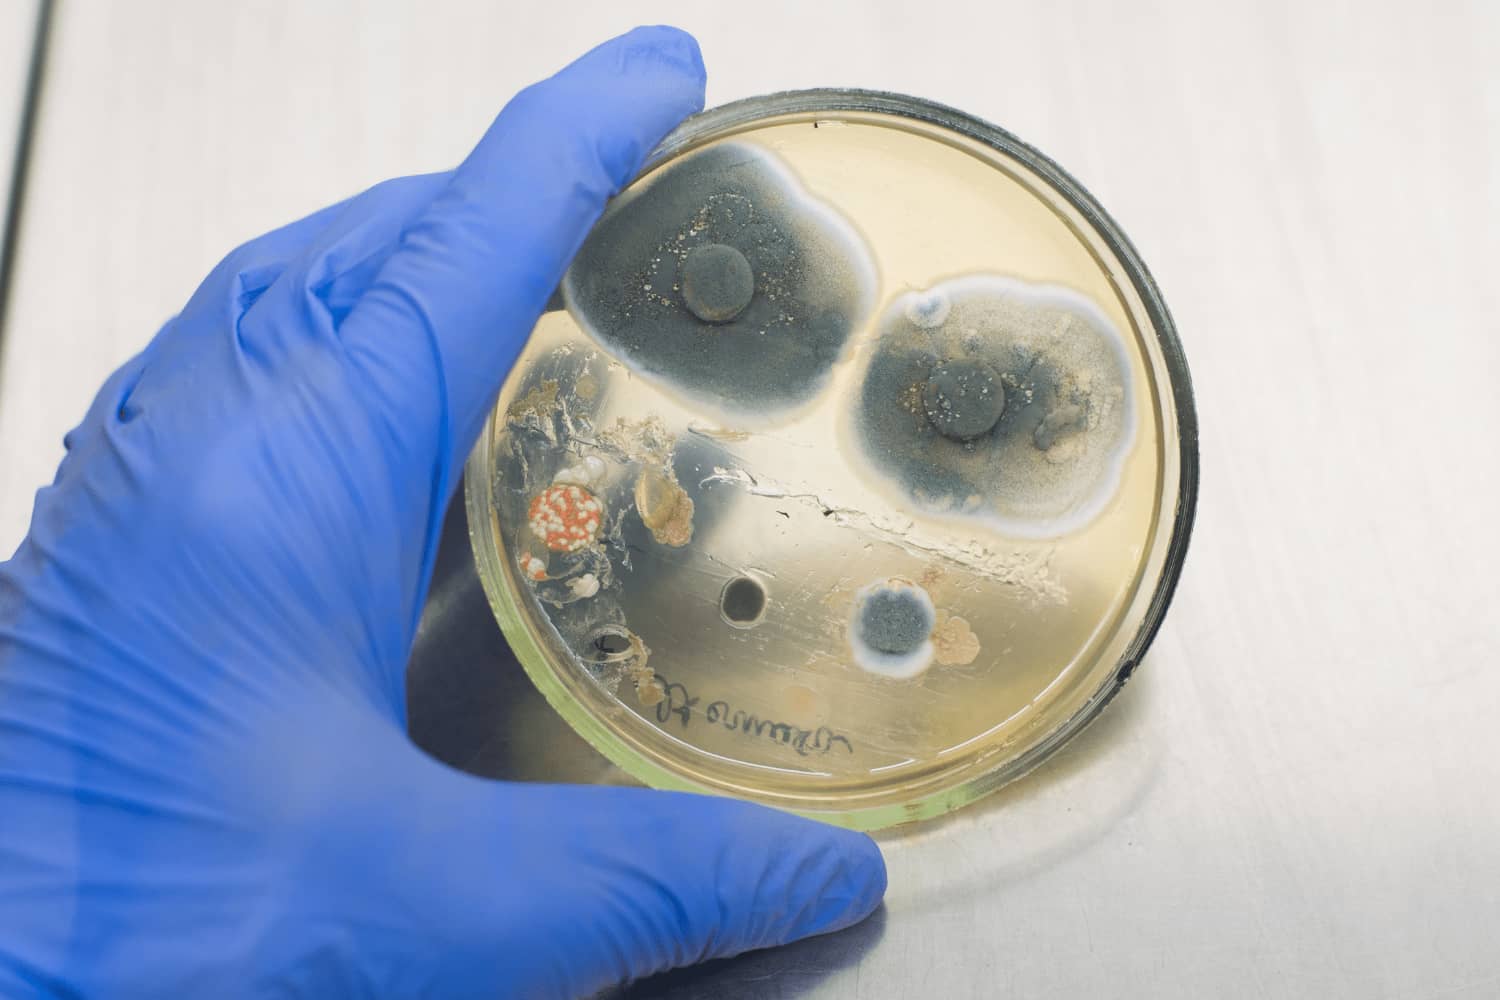

Miami Mold Lab
Reliable Residential And Commercial Miami Mold Lab Services In Miami-Dade County
Our Miami-Dade Mold Lab Prioritizes Your Health and Safety
Miami-Dade Mold Lab - Protect Your Home and Business
The majority of the damage to your building or property is caused not by what you see, but by what you don't see.
Mold is an important component of a healthy outdoor environment, but it is not so good indoors. Mold found indoors might indicate a concealed water problem in a structure. Mold growth caused by leaks and flooding may cause costly damage and contribute to poor health issues. This is why mold testing is so important. Quick Mold Labs is a well-known mold lab that serves the Miami-Dade area. Our Miami Mold Lab provides
mold testing and inspection services to homes and businesses in the Miami area.
What is Mold?
Mold is a fungus that develops in multicellular structures known as hyphae. Mold spores are produced by these hyphae, which may be found both indoors and outdoors. Although mold spores can be found everywhere, mold requires moisture to develop. As a result, mold can be especially widespread in refrigerators or showers following a water line break or flooding. There are dozens of distinct mold types; some are utilized to make common things like medication (namely penicillin) and food. However, mold may be harmful when it develops in your house or business, causing property damage as well as health problems.
How Does Mold Grow Indoors?
Mold may be found both indoors and outdoors, but it can get into your house through open doors, windows, vents, and heating and cooling systems. Mold in the air may attach itself to clothing, shoes, and pets and be brought inside. Mold spores will develop if they land in areas where there is excessive moisture, such as leaks in roofs, pipes, walls, plant pots, or areas where there has been flooding. Wet cellulose materials, such as paper and paper goods, cardboard, ceiling tiles, wood, and wood products, are also ideal for mold growth. Mold development is frequently supported by other elements such as dust, paints, wallpaper, insulation materials, drywall, carpet, fabric, and upholstery.
How Can Mold Harm Us?
Toxic mold spores can make their way into our lungs, where they can become trapped and die, leaving us sick. Some spores may not directly enter our lungs, but instead release poisonous chemicals that can cling to other particles, making us unwell. Spores of black mold (the notorious Stachybotrys chartarum) is an example of such a species.
How Does Mold Damage Your Building or Home?
The mold's body develops and spreads inside the substrate of damp construction materials, weakening or decaying them. Meruliporia, which causes indoor wood rot, and Aspergillus, which degrades drywall, are two prevalent and harmful molds. Mold spores are released into the environment by exposed surface mold and can damage us.
Doral Mold Lab Testing
There are three main types of mold testing:
- Air testing: Air sampling test determines the quantity of mold spores in the air in your house. Air samples are collected and then analyzed under a microscope. Even if you can't see the mold development, air testing can tell you whether you have a mold problem. The number of mold spores in the air can change dramatically in a short period of time, resulting in different results at various periods.
- Surface testing: Surface testing is collecting samples from household surfaces in order to determine the quantity of mold growth and spores deposited throughout the residence. Swabbing or tape lifting is commonly used to gather samples. After that, the sample is analyzed in a laboratory. As with air testing, the findings might vary because mold growth and spores are not equally distributed over surfaces in the home and can alter over time. Surface tests, unlike air tests, cannot determine the exact concentration of mold spores in the air.
- Bulk testing: Bulk testing entails gathering stuff from your house. The material is then sent to a laboratory to be inspected under a microscope for mold particles. Bulk testing may determine whether you have a mold problem and provide an estimate of the concentration of mold particles in your house.
Ideally, we recommend all three types of testing since each has its own strengths and weaknesses, but we evaluate each and every situation before determining what is needed.
Mold Inspection Before Testing
You should do a comprehensive mold inspection of your house before proceeding with mold testing. If the examination reveals MOLD, you typically do not need to do
mold testing. You can instead go to the mold removal stage. However, if you couldn't discover any mold but still believe you have a mold problem, or if you found some mold but believe there is more concealed or that it may be dangerous, it's time to turn to mold testing.
Mold Testing after Removing Mold
Mold testing is also beneficial after mold has been removed from your house. You can ensure that the mold eradication was successful by testing. Surface sampling can reveal whether or not a mold-infested area has been thoroughly cleansed. Air testing may also show that mold spores in your home's air have been reduced to a safe level following mold removal.
How to Collect a Mold Lab Sample
If you already have mold growth, you should contact Quick Mold Labs Mold Inspector or take a bulk sample yourself and send it to our Doral mold lab.
Mold Lab Results and Limitations
Our Mold Lab analysis is only the first step toward resolving a mold problem. Remember that water is the source of the disease, and home mold is simply a symptom. The results of the analysis are restricted and must be understood in the context of the setting in which the sample was obtained. Keep in mind that a sample may not be representative of all mold species present since certain species may be concealed in damp wall cavities.
Mold Lab Analysis and Identification
Mold analysis is an art as well as a science. Quick Mold Lab's primary objective is to provide you with the finest quality findings possible, especially if the samples comprise challenging, non-textbook specimens.
#1 Mold Lab Testing and Inspection
Call our highly experienced team if you discover a mold problem in your commercial or residential property. We undertake extensive mold testing to pinpoint the specific location of the fungal colonies and the source of their growth. In addition, we provide personalized solutions to meet the problem.
Here at Quick mold labs, we are dedicated to taking the hassle out of mold testing and mold inspection. We offer trusted and professional technicians who have decades of experience in the field as well as the best technology, equipment, and training to handle any and all mold-related issues. Even though our team is here to get rid of all your mold damage issues, our main concern is your health and safety.
Contact Quick Mold Labs
mold testing experts for prompt testing. Our highly educated professionals utilize cutting-edge technology and non-invasive ways to precisely identify mold.
Get A Free Estimate
By filling out the form below
MOLD INSPECTION SERVICES:
- Licensed Professionals
- Quick & Effective
- Non-Invasive Approach